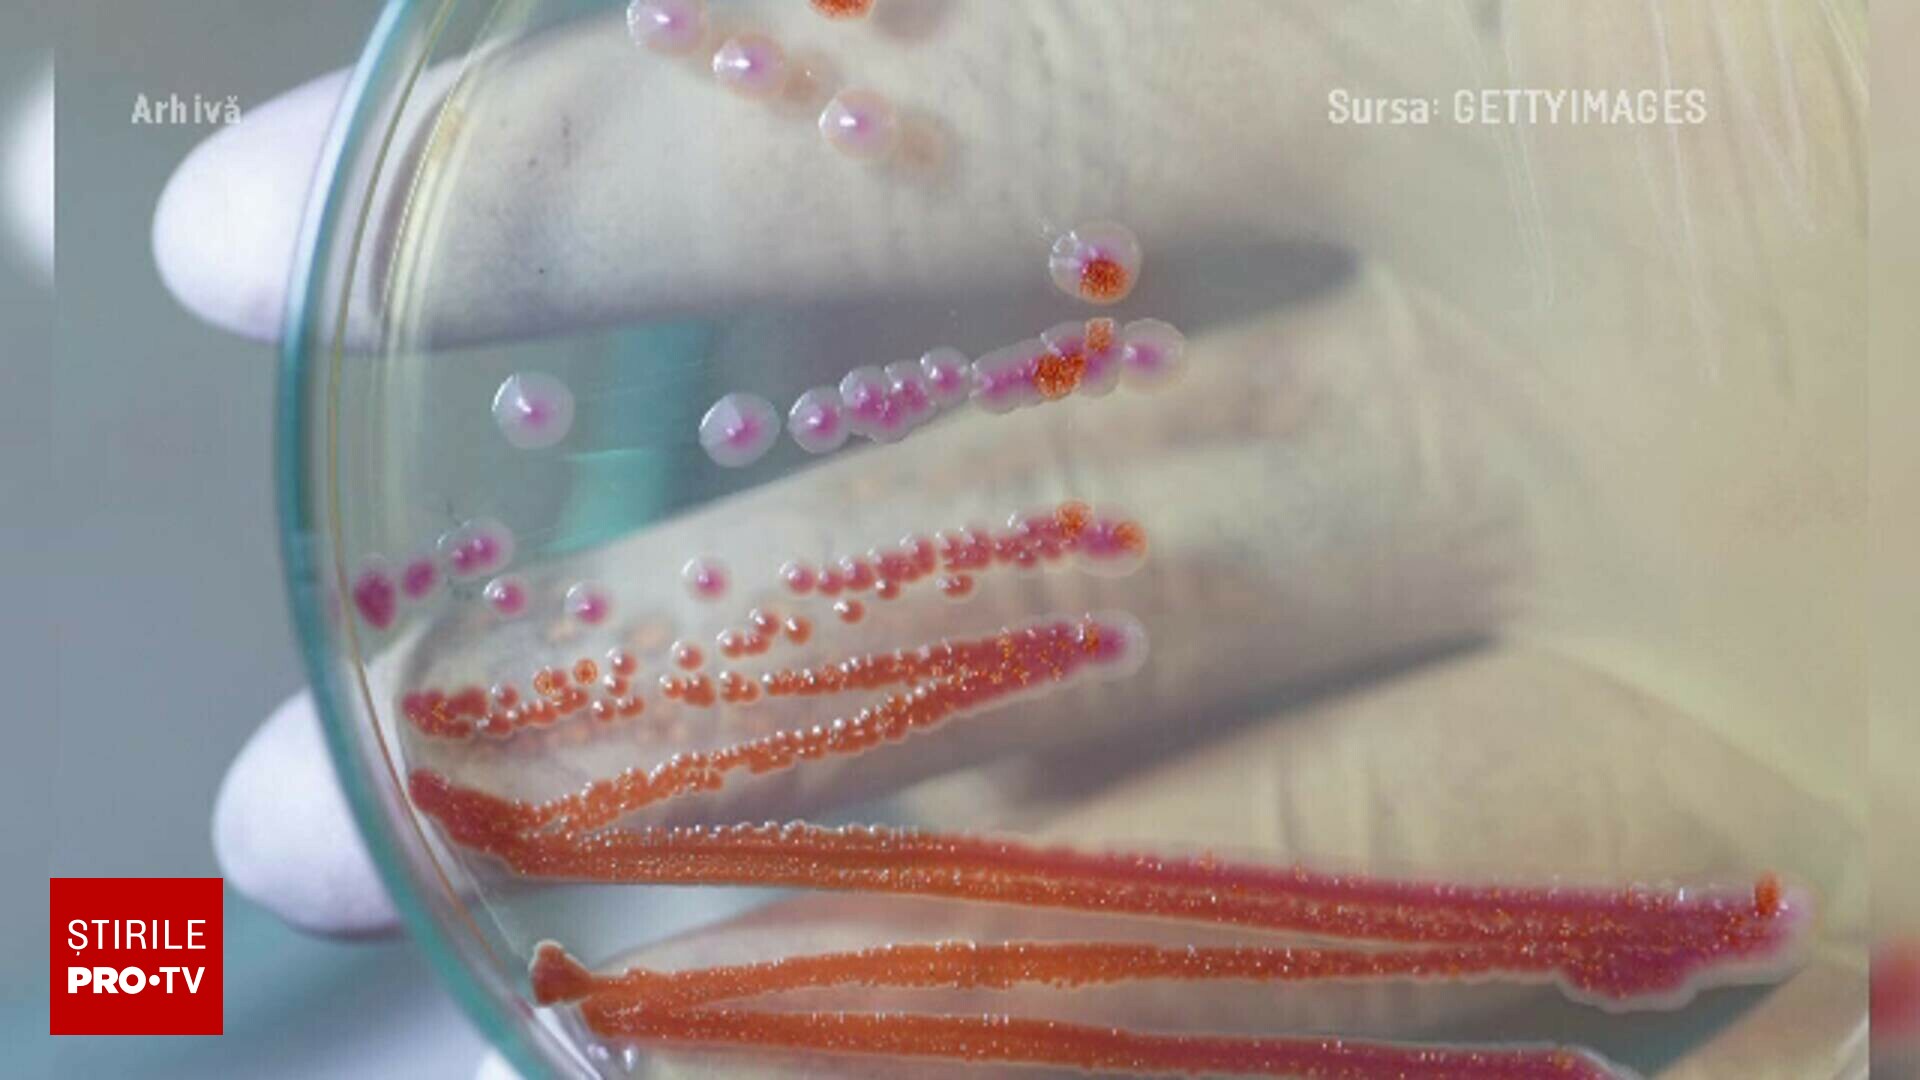

Mii de manifestanți sunt în stradă pentru a treia zi consecutiv în multiple orașe, cerând justiție independentă și reforme reale.
Printre revendicări se numără demisia unor oficiali cu responsabilități în sistemul judiciar și o limitare a influențelor politice asupra magistraților.
Protestele au fost motivate de dezvăluiri privind presiuni și nereguli în instanțe, iar autoritățile au anunțat verificări în acest sens.
Motivul selecției: Protestele afectează societatea civilă și solicită o reformă esențială a justiției.
Pagina dedicată pentru „Deficitul bugetar, la corupți în buzunar”. A treia zi de proteste în București și în marile orașe: peste 5.000 de manifestanți pentru justiție corectă